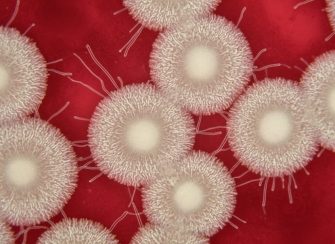

25 апреля состоится муниципальный этап Спартакиады
18 апреля прошли районные соревнования по уличному
Сибирская язва – остро протекающее заболевание всех
ВС России ударили по вторгшейся в 2024 году в Курскую
Ростовская область присоединится к масштабному Всероссийскому
На 946-м километре федеральной автодороги «Дон» на
В ходе проведения патриотической кампании «Дон помнит»
Депутаты донского парламента приняли областной закон
Торжественное шествие, посвященное Дню Победы, состоится
Депутаты донского парламента приняли закон, направленный
Уже с мая часть пенсионеров получит дополнительные
20 апреля 2026 года стадион «Локомотив» в Ростове-на-Дону
Американский солнечный окунь, агрессивный хищник из
Тяжелые огнеметные системы играют ключевую роль в зоне
Руководитель исполкома Народного фронта Михаил Кузнецов
Председатель Законодательного Собрания Ростовской области
Ученики школы № 1 из города Семикаракорска в составе
Депутаты приняли региональный закон, устанавливающий
Этот турнир был посвящен 81-й годовщине Победы в Великой
Весна — время активного роста озимых зерновых культур
Спасательные службы на Дону приступили к обустройству
В семикаракорском детском саду «Росинка» прошла необычная
Дон расцветает! В эти выходные фестиваль экологического
В рамках национального проекта «Семья» на базе МБУ
Ученые из АзНИИРХ прогнозируют значительное сокращение
Командир взвода в одиночку удерживал позицию, несмотря
Новости Семикаракорского района
Свежие и актуальные новости Семикаракорского района. Вся информация о событиях, мероприятиях, происшествиях